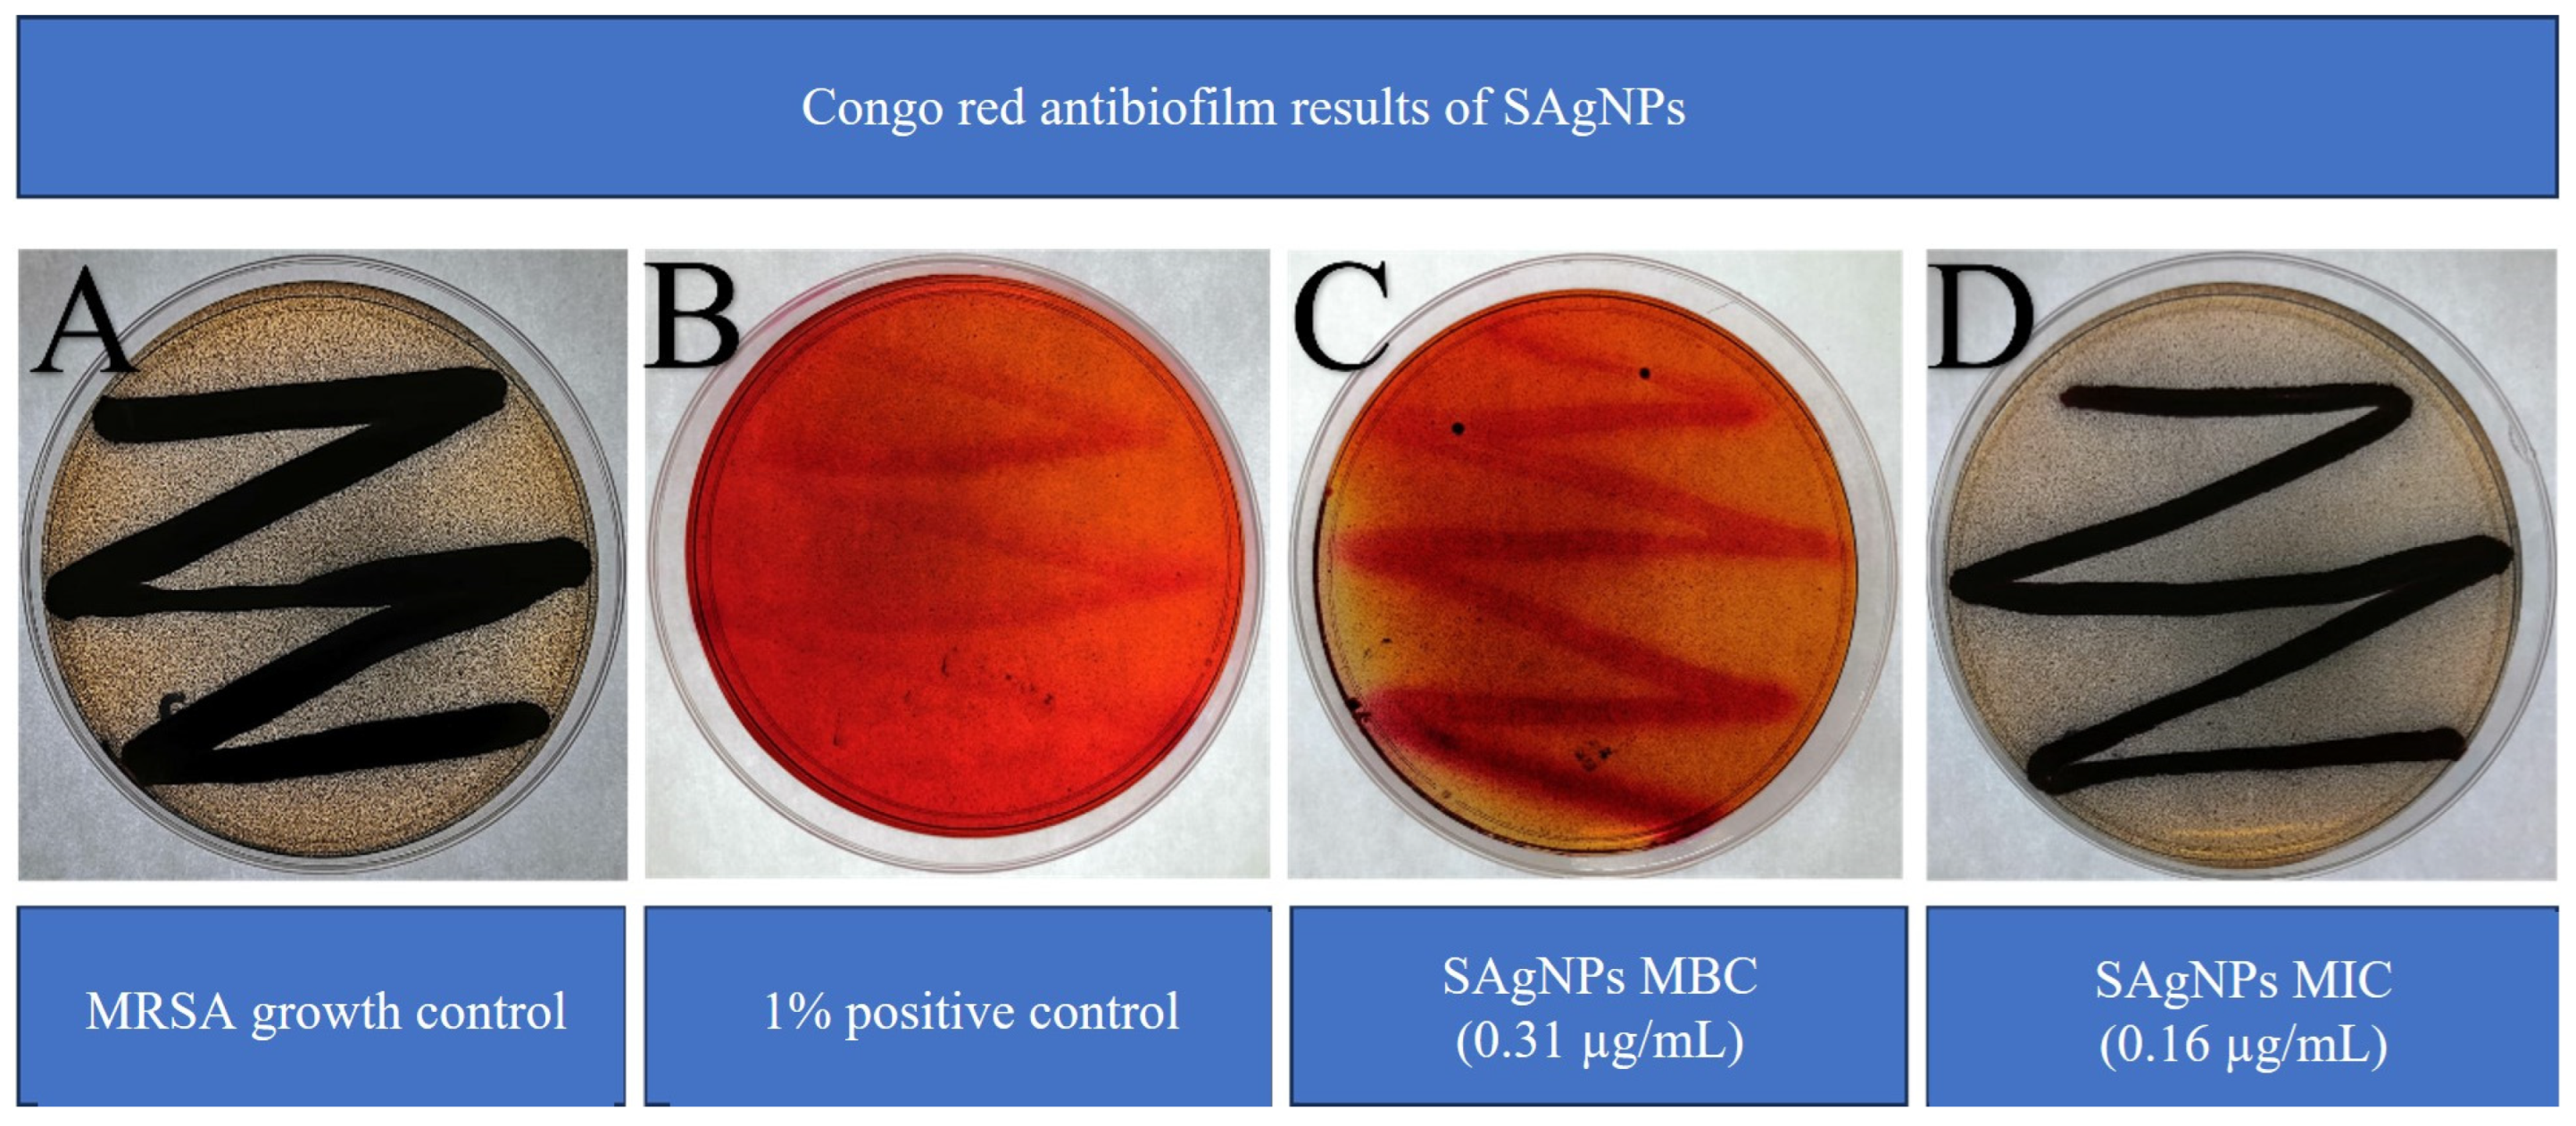
Inorganics 13 00178 g007 Inorganics 13 00178 g007

Efficacy of Stenocereus queretaroensis-Derived Silver Nanoparticles Against Methicillin-Resistant Staphylococcus aureus Biofilms: Synthesis and Antibiofilm Activity
Abstract
1. Introduction
2. Results
2.1. Nanoparticle Synthesis for Optimization
2.2. Antimicrobial Activity of SAgNPs Against MRSA
2.3. Quantitative Antibiofilm Activity on Plates
2.4. Antibiofilm Activity in Congo Red Agar
2.5. Molecular Docking Results
3. Discussion
4. Materials and Methods
4.1. Nanoparticle Synthesis and Optimization
4.2. Nanoparticle Characteristics
4.3. Antimicrobial Activity
Minimum Inhibitory Concentration (MIC) and Minimum Bactericidal Concentration (MBC)
4.4. Antibiofilm Activity
4.4.1. Quantitative Antibiofilm Activity
4.4.2. Qualitative Antibiofilm Activity in Agar
4.5. Molecular Docking
In Silico Study
5. Conclusions
Author Contributions
Funding
Institutional Review Board Statement
Informed Consent Statement
Data Availability Statement
Conflicts of Interest
References
- Hutchings, M.I.; Truman, A.W.; Wilkinson, B. Antibiotics: Past, present and future. Curr. Opin. Microbiol. 2019, 51, 72–80. [Google Scholar] [CrossRef]
- Dodds, D.R. Antibiotic resistance: A current epilogue. Biochem. Pharmacol. 2017, 134, 139–146. [Google Scholar] [CrossRef] [PubMed]
- Woolhouse, M.; Waugh, C.; Perry, M.R.; Nair, H. Global disease burden due to antibiotic resistance—state of the evidence. J. Glob. Health 2016, 6, 010306. [Google Scholar] [CrossRef]
- Silva, V.; Almeida, L.; Gaio, V.; Cerca, N.; Manageiro, V.; Caniça, M.; Capelo, J.L.; Igrejas, G.; Poeta, P. Biofilm formation of multidrug-resistant MRSA strains isolated from different types of human infections. Pathogens 2021, 10, 970. [Google Scholar] [CrossRef] [PubMed]
- Schilcher, K.; Horswill, A.R. Staphylococcal Biofilm Development: Structure, Regulation, and Treatment Strategies. Microbiol. Mol. Biol. Rev. 2020, 84, e00026-19. [Google Scholar] [CrossRef] [PubMed]
- Uddin, T.M.; Chakraborty, A.J.; Khusro, A.; Zidan, B.R.M.; Mitra, S.; Emran, T.B.; Dhama, K.; Ripon, K.H.; Gajdács, M.; Sahibzada, M.U.K.; et al. Antibiotic resistance in microbes: History, mechanisms, therapeutic strategies and future prospects. J. Infect. Public Health 2021, 14, 1750–1766. [Google Scholar] [CrossRef] [PubMed]
- Asadipour, E.; Asgari, M.; Mousavi, P.; Piri-Gharaghie, T.; Ghajari, G.; Mirzaie, A. Nano-biotechnology and challenges of drug delivery system in cancer treatment pathway. Chem. Biodivers. 2023, 20, e202201072. [Google Scholar] [CrossRef]
- Lee, S.H.; Jun, B.-H. Silver nanoparticles: Synthesis and application for nanomedicine. Int. J. Mol. Sci. 2019, 20, 865. [Google Scholar] [CrossRef]
- Rafique, M.; Sadaf, I.; Rafique, M.S.; Tahir, M.B. A review on green synthesis of silver nanoparticles and their applications. Artif. Cells Nanomed. Biotechnol. 2017, 45, 1272–1291. [Google Scholar] [CrossRef]
- Das, P.; Ghosh, S.; Nayak, B. Phyto-fabricated nanoparticles and their anti-biofilm activity: Progress and current status. Front. Nanotechnol. 2021, 3, 739286. [Google Scholar] [CrossRef]
- Hosseini, M.; Shapouri Moghaddam, A.; Derakhshan, S.; Hashemipour, S.M.A.; Hadadi-Fishani, M.; Pirouzi, A.; Khaledi, A. Correlation between biofilm formation and antibiotic resistance in MRSA and MSSA isolated from clinical samples in Iran: A systematic review and meta-analysis. Microb. Drug Resist. 2020, 26, 1071–1080. [Google Scholar] [CrossRef] [PubMed]
- Padilla-Camberos, E.; Sanchez-Hernandez, I.M.; Torres-Gonzalez, O.R.; Ramirez-Rodriguez, P.; Diaz, E.; Wille, H.; Flores-Fernandez, J.M. Biosynthesis of silver nanoparticles using Stenocereus queretaroensis fruit peel extract: Study of antimicrobial activity. Materials 2021, 14, 4543. [Google Scholar] [CrossRef] [PubMed]
- Kleijnen, J.P. Response surface methodology for constrained simulation optimization: An overview. Simul. Model. Pract. Theory 2008, 16, 50–64. [Google Scholar] [CrossRef]
- González-Garibay, A.S.; Vallejo-Cardona, A.A.; Villarreal-Amézquita, A.A.; Sánchez-Hernández, I.M.; Torres-González, O.R.; Padilla-Camberos, E. The In Vitro Cytotoxic Potential of Biosynthesized Silver Nanoparticles in MIA PaCa-2 Cells Supported with an In Silico Study. Inorganics 2024, 12, 317. [Google Scholar] [CrossRef]
- Do, B.L.; Bui, T.H.; Ho, T.G.-T.; Duong, N.L.; Nguyen, V.M.; Dang-Bao, T.; Nguyen, T.; Phuong, P.H. Green synthesis of nanosilver and its antibacterial activity against methicillin-resistant Staphylococcus aureus. J. Saudi Chem. Soc. 2023, 27, 101722. [Google Scholar] [CrossRef]
- Murray, C.J.; Ikuta, K.S.; Sharara, F.; Swetschinski, L.; Aguilar, G.R.; Gray, A.; Tasak, N. Global burden of bacterial antimicrobial resistance in 2019: A systematic analysis. Lancet 2022, 399, 629–655. [Google Scholar] [CrossRef]
- Lakhundi, S.; Zhang, K. Methicillin-resistant Staphylococcus aureus: Molecular characterization, evolution, and epidemiology. Clin. Microbiol. Rev. 2018, 31, e00020-18. [Google Scholar] [CrossRef]
- Li, M.; Liu, Y.; Gong, Y.; Yan, X.; Wang, L.; Zheng, W.; Zhao, Y. Recent advances in nanoantibiotics against multidrug-resistant bacteria. Nanoscale Adv. 2023, 5, 6278–6317. [Google Scholar] [CrossRef] [PubMed]
- Hasnain, M.S.; Javed, M.N.; Alam, M.S.; Rishishwar, P.; Rishishwar, S.; Ali, S.; Beg, S. Purple heart plant leaves extract-mediated silver nanoparticle synthesis: Optimization by Box–Behnken design. Mater. Sci. Eng. C 2019, 99, 1105–1114. [Google Scholar] [CrossRef]
- Salah, R.; Karmy, M.; Abdelraouf, A.; Kotb, S. Evaluation of the bactericidal effect of silver nanoparticles against methicillin resistant Staphylococcus aureus (MRSA) and methicillin sensitive Staphylococcus aureus (MSSA) strains isolated from mastitic milk of small ruminants and their surrounding environment in Aswan, Egypt. J. Vet. Med. Res. 2020, 27, 143–151. [Google Scholar] [CrossRef]
- Ansari, M.A.; Khan, H.M.; Khan, A.A.; Cameotra, S.S.; Alzohairy, M.A. Anti-biofilm efficacy of silver nanoparticles against MRSA and MRSE isolated from wounds in a tertiary care hospital. Indian J. Med. Microbiol. 2015, 33, 101–109. [Google Scholar] [CrossRef] [PubMed]
- Masimen, M.A.A.; Harun, N.A.; Maulidiani, M.; Ismail, W.I.W. Overcoming methicillin-resistance Staphylococcus aureus (MRSA) using antimicrobial peptides-silver nanoparticles. Antibiotics 2022, 11, 951. [Google Scholar] [CrossRef] [PubMed]
- Kalishwaralal, K.; BarathManiKanth, S.; Pandian, S.R.K.; Deepak, V.; Gurunathan, S. Silver nanoparticles impede the biofilm formation by Pseudomonas aeruginosa and Staphylococcus epidermidis. Colloids Surf. B Biointerfaces 2010, 79, 340–344. [Google Scholar] [CrossRef]
- Hunaiza, F.; Hamdani, S.D.A.; Ahmed, M.; Rajput, T.A.; Gul, A.; Amir, R.; Babar, M.M. Anti-MRSA potential of biogenic silver nanoparticles synthesized from hydroponically grown Foeniculum vulgare. Phytomedicine Plus 2023, 3, 100415. [Google Scholar] [CrossRef]
- Barabadi, H.; Mojab, F.; Vahidi, H.; Marashi, B.; Talank, N.; Hosseini, O.; Saravanan, M. Green synthesis, characterization, antibacterial and biofilm inhibitory activity of silver nanoparticles compared to commercial silver nanoparticles. Inorg. Chem. Commun. 2021, 129, 108647. [Google Scholar] [CrossRef]
- Ansari, M.A.; Kalam, A.; Al-Sehemi, A.G.; Alomary, M.N.; AlYahya, S.; Aziz, M.K.; Srivastava, S.; Alghamdi, S.; Akhtar, S.; Almalki, H.D.; et al. Counteraction of biofilm formation and antimicrobial potential of Terminalia catappa functionalized silver nanoparticles against Candida albicans and multidrug-resistant gram-negative and gram-positive bacteria. Antibiotics 2021, 10, 725. [Google Scholar] [CrossRef] [PubMed]
- da Cunha, K.F.; Oliveira Garcia, M.; Allend, S.O.; de Albernaz, D.F.T.; Panagio, L.A.; Neto, A.C.P.S.; Oliveira, T.L.; Hartwig, D.D. Biogenic silver nanoparticles: In vitro activity against Staphylococcus aureus methicillin-resistant (MRSA) and multidrug-resistant coagulase-negative Staphylococcus (CoNS). Braz. J. Microbiol. 2023, 54, 2641–2650. [Google Scholar] [CrossRef]
- Almatroudi, A.; Khadri, H.; Azam, M.; Rahmani, A.H.; Al Khaleefah, F.K.; Khateef, R.; Allemailem, K.S. Antibacterial, antibiofilm and anticancer activity of biologically synthesized silver nanoparticles using seed extract of Nigella sativa. Processes 2020, 8, 388. [Google Scholar] [CrossRef]
- Shahba, D.S.A.; Shalaby, M.M.; Ezzand, H.A.; Hussein, M.Z. Inhibitory effect of silver nanoparticles on biofilm production by methicillin resistant staphylococci. Egypt. J. Med. Microbiol. 2017, 26, 49–54. [Google Scholar] [CrossRef]
- Moulavi, P.; Noorbazargan, H.; Dolatabadi, A.; Foroohimanjili, F.; Tavakoli, Z.; Mirzazadeh, S.; Ashrafi, F. Antibiofilm effect of green engineered silver nanoparticles fabricated from Artemisia scoporia extract on the expression of icaA and icaR genes against multidrug-resistant Staphylococcus aureus. J. Basic Microbiol. 2019, 59, 701–712. [Google Scholar] [CrossRef]
- de Lacerda Coriolano, D.; de Souza, J.B.; Bueno, E.V.; de Fátima Ramos dos Santos Medeiros, S.M.; Cavalcanti, I.D.L.; Cavalcanti, I.M.F. Antibacterial and antibiofilm potential of silver nanoparticles against antibiotic-sensitive and multidrug-resistant Pseudomonas aeruginosa strains. Braz. J. Microbiol. 2021, 52, 267–278. [Google Scholar] [CrossRef] [PubMed]
- Swidan, N.S.; Hashem, Y.A.; Elkhatib, W.F.; Yassien, M.A. Antibiofilm activity of green synthesized silver nanoparticles against biofilm associated enterococcal urinary pathogens. Sci. Rep. 2022, 12, 3869. [Google Scholar] [CrossRef] [PubMed]
- Thappeta, K.R.V.; Zhao, L.N.; Nge, C.E.; Crasta, S.; Leong, C.Y.; Ng, V.; Ng, S.B. In-silico identified new natural sortase inhibitors disrupt S. aureus biofilm formation. Int. J. Mol. Sci. 2020, 21, 8601. [Google Scholar] [CrossRef] [PubMed]
- Ambade, S.S.; Gupta, V.K.; Bhole, R.P.; Khedekar, P.B.; Chikhale, R.V. A review on five and six-membered heterocyclic compounds targeting the penicillin-binding protein 2 (PBP2A) of Methicillin-resistant Staphylococcus aureus (MRSA). Molecules 2023, 28, 7008. [Google Scholar] [CrossRef] [PubMed]
- Lim, D.; Strynadka, N. Structural basis for the β lactam resistance of PBP2a from methicillin-resistant Staphylococcus aureus. Nat. Struct. Mol. Biol. 2022, 9, 870–876. [Google Scholar] [CrossRef]
- Tabassum, R.; Kousar, S.; Mustafa, G.; Jamil, A.; Attique, S.A. In Silico Method for the Screening of Phytochemicals against methicillin-resistant Staphylococcus aureus. BioMed Res. Int. 2023, 2023, 5100400. [Google Scholar] [CrossRef]
- Anwer, R. Identification of Small Molecule Inhibitors of Penicillin-Binding Protein 2a of Methicillin-Resistant Staphylococcus aureus for the Therapeutics of Bacterial Infection: Inhibitors of PBP2a of Methicillin-Resistant S. aureus. Cell Mol. Biol. 2024, 70, 40–47. [Google Scholar] [CrossRef]
- Rani, N.; Vijayakumar, S.; Velan, L.P.T.; Arunachalam, A. Quercetin 3-O-rutinoside mediated inhibition of PBP2a: Computational and experimental evidence to its anti-MRSA activity. Mol. Biosyst. 2014, 10, 3229–3237. [Google Scholar] [CrossRef]
- Mutie Musila, F.; Gitau, G.W.; Amwayi, P.W.; Kingoo, J.M.; Kinyanyi, D.B.; Njeru, P.N. Pharmacophore modeling, 2D-QSAR, Molecular Docking and ADME studies for the discovery of inhibitors of PBP2a in MRSA. BioRxiv 2025, 2, 636556. [Google Scholar] [CrossRef]
- Alwan, S.M. Computational Calculations of Molecular Properties and Molecular Docking of New and Reference Cephalosporins on Penicillin Binding Proteins and Various β-Lactamases. J. Pharm. Pharmacol. 2016, 4, 212–225. [Google Scholar] [CrossRef][Green Version]
- Ferdous, Z.; Nemmar, A. Health Impact of Silver Nanoparticles: A Review of the Biodistribution and Toxicity Following Various Routes of Exposure. Int. J. Mol. Sci. 2020, 21, 2375. [Google Scholar] [CrossRef]
- Baqer, S.H.; Al-Younis, Z.K.; Al-Shawi, S.G. Extracting Quercetin from Different Plant Sources, Purifying It Using Different Extraction Methods (Chemical, Physical, and Enzymatic), and Measuring Its Antioxidant Activity. Front. Biosci. (Elite Ed.) 2024, 16, 35. [Google Scholar] [CrossRef]
- Padilla-Camberos, E.; Juárez-Navarro, K.J.; Sanchez-Hernandez, I.M.; Torres-Gonzalez, O.R.; Flores-Fernandez, J.M. Toxicological Evaluation of Silver Nanoparticles Synthesized with Peel Extract of Stenocereus queretaroensis. Materials 2022, 15, 5700. [Google Scholar] [CrossRef]
- Merghni, A.; Lassoued, M.A.; Noumi, E.; Hadj Lajimi, R.; Adnan, M.; Mastouri, M.; Snoussi, M. Cytotoxic activity and antibiofilm efficacy of biosynthesized silver nanoparticles against methicillin-resistant Staphylococcus aureus strains colonizing cell phones. Can. J. Infect. Dis. Med. Microbiol. 2022, 2022, 9410024. [Google Scholar] [CrossRef]
- Rahim, K.A.A.A.; Mohamed, A.M.A. Bactericidal and antibiotic synergistic effect of nanosilver against methicillin-resistant Staphylococcus aureus. Jundishapur J. Microbiol. 2015, 8, e25867. [Google Scholar] [CrossRef]
- dos Santos, E.M.P.; Martins, C.C.B.; de Oliveira Santos, J.V.; da Silva, W.R.C.; Silva, S.B.C.; Pelagio-Flores, M.A.; Galembeck, A.; Cavalcanti, I.M.F. Silver nanoparticles-chitosan composites activity against resistant bacteria: Tolerance and biofilm inhibition. J. Nanopart. Res. 2021, 23, 196. [Google Scholar] [CrossRef]
- Kaiser, T.D.L.; Pereira, E.M.; Dos Santos, K.R.N.; Maciel, E.L.N.; Schuenck, R.P.; Nunes, A.P.F. Modification of the congo red agar method to detect biofilm production by Staphylococcus epidermidis. Diagn. Microbiol. Infect. 2013, 75, 235–239. [Google Scholar] [CrossRef]
- Qiu, X.; Janson, C.A.; Smith, W.W.; Green, S.M.; McDevitt, P.; Johanson, K.; Jarvest, R.L. Crystal structure of Staphylococcus aureus tyrosyl-tRNA synthetase in complex with a class of potent and specific inhibitors. Protein Sci. 2001, 10, 2008–2016. [Google Scholar] [CrossRef]
- Castro-Enríquez, D.D.; Montaño-Leyva, B.; Del Toro-Sánchez, C.L.; Juárez-Onofre, J.E.; Carvajal-Millán, E.; López-Ahumada, G.A.; Barreras-Urbina, C.G.; Tapia-Hernández, J.A.; Rodríguez-Félix, F. Effect of ultrafiltration of pitaya Extract (Stenocereus thurberi) on its phytochemical content, antioxidant capacity, and UPLC-DAD-MS profile. Molecules 2020, 25, 281. [Google Scholar] [CrossRef]
- Morosini, M.I.; Díez-Aguilar, M.; Cantón, R. Mechanisms of action and antimicrobial activity of ceftobiprole. Rev. Esp. Quimioter. 2019, 32, 3–10. [Google Scholar]
- Neupane, N.P.; Kushwaha, A.K.; Karn, A.K.; Khalilullah, H.; Khan, M.M.U.; Kaushik, A.; Verma, A. Antibacterial efficacy of biofabricated silver nanoparticles of aerial part of Moringa oleifera lam: Rapid green synthesis, in-vitro and in-silico screening. Biocatal. Agric. Biotechnol. 2022, 39, 102229. [Google Scholar] [CrossRef]

| Samples | DG | Amino Acids Interacting with Hydrogen Bonds (HBs) |
|---|---|---|
| Ceftobiprole | −6.66 | ASP39 C: B (4.59); LYS40 C: B (4.97); ASN71 C: B(3.61); VAL75 C: B (5.51) |
| Quercetin | −5.48 | ASN146 C: B (3.88); LYS148 C: A (4.75); GLU239 C: A (4.81; 5.06); ARG298 C: A (5.98); LYS318 C: A (4.12); y C: B (5.39). |
| Parameter | Method | SAgNPs Characteristics |
|---|---|---|
| Surface plasmon resonance | Ultraviolet–Visible Spectroscopy | Maximum absorbance peak at 420 nm |
| Morphology/Shape | Transmission Electron Microscopy | Spherical |
| Size | Dynamic Light Scattering | Average size of 48.8 nm |
| Functional groups | Fourier Transform Infrared Spectroscopy | Presence of OH groups |
| Structure | X-Ray Diffraction | Presence of silver and silver chloride |
| Biocompatibility | Cell Culture and Animal Models | Non-toxic |
| Name | Formula | No. CID | Structure |
|---|---|---|---|
| Ceftobiprole | C20H22N8O6S2 | 135413542 | ![]() |
| Quercetin | C15H10O7 | 5280343 | ![]() |
Disclaimer/Publisher’s Note: The statements, opinions and data contained in all publications are solely those of the individual author(s) and contributor(s) and not of MDPI and/or the editor(s). MDPI and/or the editor(s) disclaim responsibility for any injury to people or property resulting from any ideas, methods, instructions or products referred to in the content. |
© 2025 by the authors. Licensee MDPI, Basel, Switzerland. This article is an open access article distributed under the terms and conditions of the Creative Commons Attribution (CC BY) license (https://creativecommons.org/licenses/by/4.0/).
Share and Cite
González-Garibay, A.S.; Sánchez-Hernández, I.M.; Villarreal-Amézquita, A.A.; Torres-González, O.R.; Padilla-Camberos, E. Efficacy of Stenocereus queretaroensis-Derived Silver Nanoparticles Against Methicillin-Resistant Staphylococcus aureus Biofilms: Synthesis and Antibiofilm Activity. Inorganics 2025, 13, 178. https://doi.org/10.3390/inorganics13060178
González-Garibay AS, Sánchez-Hernández IM, Villarreal-Amézquita AA, Torres-González OR, Padilla-Camberos E. Efficacy of Stenocereus queretaroensis-Derived Silver Nanoparticles Against Methicillin-Resistant Staphylococcus aureus Biofilms: Synthesis and Antibiofilm Activity. Inorganics. 2025; 13(6):178. https://doi.org/10.3390/inorganics13060178
Chicago/Turabian StyleGonzález-Garibay, Angélica Sofía, Iván Moisés Sánchez-Hernández, Ariadna Abigail Villarreal-Amézquita, Omar Ricardo Torres-González, and Eduardo Padilla-Camberos. 2025. "Efficacy of Stenocereus queretaroensis-Derived Silver Nanoparticles Against Methicillin-Resistant Staphylococcus aureus Biofilms: Synthesis and Antibiofilm Activity" Inorganics 13, no. 6: 178. https://doi.org/10.3390/inorganics13060178
APA StyleGonzález-Garibay, A. S., Sánchez-Hernández, I. M., Villarreal-Amézquita, A. A., Torres-González, O. R., & Padilla-Camberos, E. (2025). Efficacy of Stenocereus queretaroensis-Derived Silver Nanoparticles Against Methicillin-Resistant Staphylococcus aureus Biofilms: Synthesis and Antibiofilm Activity. Inorganics, 13(6), 178. https://doi.org/10.3390/inorganics13060178



